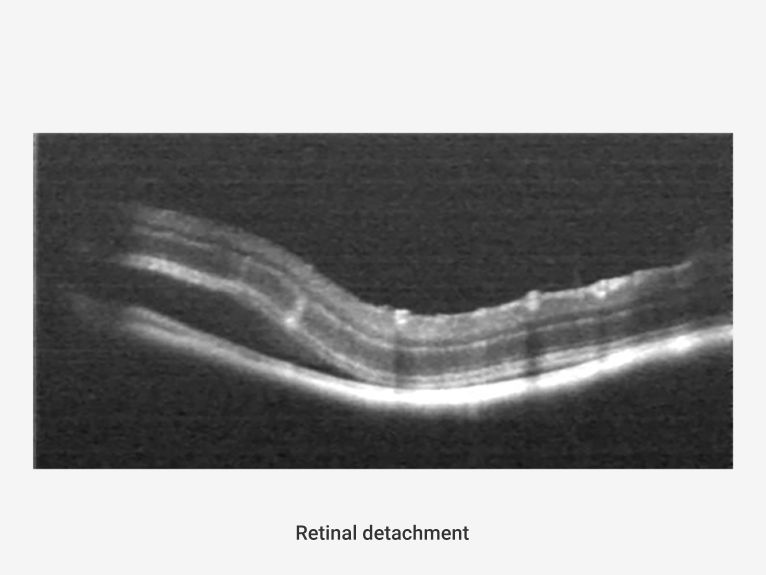

Saris
Non-invasive in-vivo imaging platform for research in ophthalmology and interdisciplinary fields
1.8μm Retinal resolution with 7 modalities












100° Ultra-widefield imaging
AI-based imaging processing and data analysis

OCT:
Automatic layer segmentation of the full retina.
Three-dimensional reconstruction.
OCTA:
Blood flow density
Skeletal density
Vessel tortuosity
Average vascular diameter
Thickness of each layer
Thickness maps of the entire and individual layers














Multi-Species adaption
Zebra fish
C57BL/6
Guinea pig
SD Rat
Chicken
Rabbit
Pig
Case sharing

Saris is a Non-invasive in-vivo imaging platform for research in
ophthalmology and interdisciplinary fields.